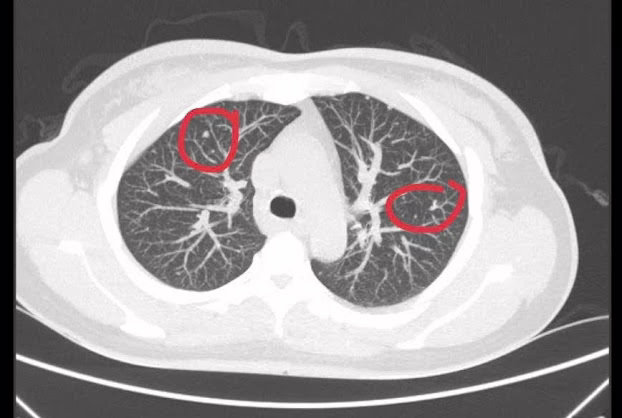

Ngày 18/12/2015, báo Người lao động đưa tin “Miếng dán hoạt hình Trung Quốc gây ung thư, vô sinh” với nội dung như sau:
Phthalate có trong miếng dán hoạt hình là chất độc hại có khả năng gây ung thư và vô sinh cho trẻ em, trước đó chất này đã từng được phát hiện trong sản phẩm thú nhún Trung Quốc đã từng bày bán tại Việt Nam.
Mới đây, Cục Quản lý chất lượng sản phẩm, hàng hóa (Tổng cục Tiêu chuẩn đo lường chất lượng, Bộ Khoa học và Công nghệ) vừa có cảnh báo người tiêu dùng trên toàn quốc không nên mua miếng dán đồ chơi stickers có nguồn gốc từ Trung Quốc gây ung thư và vô sinh, song trên thực tế không phải ai cũng biết đến tác hại của chúng.
Bày bán tràn lan
Không phải đến bây giờ các sản phẩm hàng hóa có xuất xứ Trung Quốc mới khiến người tiêu dùng thấp thỏm lo âu về chất lượng. Từ đồ chơi cho trẻ em với những sản phẩm gắn với bạo lực, hay đồ chơi nhựa độc hại, giờ đến cả những miếng dán hoạt hình cho trẻ em cũng được cảnh báo là không an toàn.
Khảo sát một số địa điểm bán đồ chơi của Hà Nội như Lương Văn Can, Hàng Mã, Đồng Xuân… rất dễ nhận thấy loại đồ chơi này được bày bán tràn lan. Mùa Noel sắp đến gần, không khó để bắt gặp hình ảnh những miếng dán hoạt hình, ông già Noel, cây thông, tuần lộc… với đủ màu sắc, hình dáng đa dạng và giá chỉ từ 15.000 – 30.000 đồng, được ghi rõ “Sản xuất tại Trung Quốc”.
Khi được hỏi là những hình dán này có nguy cơ gây độc hại cho người dùng hay không, chị N.T.C – chủ một cửa hàng trên phố Lương Văn Can cho biết, chúng tôi chưa thấy ai nói gì về việc miếng dán này gây độc hại. Hàng ngày số lượng sản phẩm này vẫn được bán đều, thậm chí bán buôn cho nhiều người ở các tỉnh. Tuy nhiên, chị C. cũng thẳng thắn cho rằng không lời lãi gì mấy ở mặt hàng này.
Không nên cho trẻ chơi miếng dán có xuất xứ Trung Quốc.
Không chỉ có ở những chợ đồ chơi mà ngay chính trong các nhà sách, siêu thị, kể cả các cửa hàng tạp hóa ở những khu đông dân cư cũng bày bán rất nhiều hình dán này.
Vì sao khi đã có thông tin về tính chất độc hại của sản phẩm này mà nó vẫn được bày bán tràn lan mà không có sự vào cuộc hay nhắc nhở từ các cơ quan chức năng?
Phóng viên có cuộc trao đổi với ông Nguyễn Công San, Phó Chi cục trưởng Chi cục Quản lý thị trường (QLTT) Hà Nội, ông San cho biết, sau khi có thông tin về tác hại của những sản phẩm sticker này, lực lượng QLTT đã chỉ đạo các đơn vị trực thuộc phối hợp với lực lượng công an và chính quyền địa phương, đặc biệt là quận nội thành, ra quân rà soát những nơi tập trung bán đồ chơi, tại các cổng trường học, các siêu thị, cửa hàng sách, văn phòng phẩm tịch thu mặt hàng này. Tuy nhiên, do dịp Giáng sinh sắp đến, một số cửa hàng kinh doanh đã quay trở lại bán mặt hàng này. Ông San cam kết, lực lượng QLTT sẽ tiếp tục ra quân chấn chỉnh kịp thời trong thời gian tới, để bảo đảm sức khỏe người tiêu dùng.
Tác hại thế nào?
Theo Cục Quản lý chất lượng sản phẩm hàng hóa, trên thị trường xuất hiện loại sản phẩm “miếng dán hoạt hình stickers”, qua kiểm nghiệm có chứa hàm lượng phthalates với nồng độ vượt mức cho phép gấp nhiều lần so với ngưỡng an toàn được quy định trong bộ tiêu chuẩn REACH regulation (EC). Cụ thể, trong kết quả thử nghiệm cho thấy, hàm lượng phthalates DINP là 37.390mg/kg trong khi giới hạn cho phép là 300mg/kg; còn DEHP có hàm lượng 14.100mg/kg trong khi giới hạn cho phép là 100mg/kg.
Những chất này có thể xâm nhập cơ thể bằng các tiếp xúc qua da, đường miệng và cả đường hô hấp và có khả năng là tác nhân khiến bé gái dậy thì sớm và nguyên nhân gây vô sinh ở bé trai sau này. Ngoài những tác động trên, nó còn gây ung thư, ảnh hưởng tới chức năng các cơ quan khác như gan và thận. Do đó, Cục đã đề nghị các cơ quan thông tin đại chúng cảnh báo người tiêu dùng không mua và sử dụng những sản phẩm này. Đồng thời yêu cầu cơ quan chức năng các tỉnh, thành phố kiểm tra và xử lý vi phạm theo quy định của pháp luật. Phthalate là chất độc hại có khả năng gây ung thư và vô sinh cho trẻ em, trước đó chất này đã từng được phát hiện trong sản phẩm thú nhún Trung Quốc đã từng bày bán tại Việt Nam.
Theo PGS-TS Nguyễn Duy Thịnh, Viện Công nghệ Sinh học và Thực phẩm, ĐH Bách khoa Hà Nội, những đồ dùng bằng nhựa nói chung và những loại đồ chơi bằng nhựa dành cho trẻ nhỏ nói riêng, trong thành phần của chúng không thể thiếu phthalates. Đây không phải là một chất mà là một nhóm chất, được dùng làm phụ gia để tăng độ dẻo dai của các sản phẩm nhựa, kể cả thuốc trừ sâu… Do vậy, người tiêu dùng cần đặc biệt cẩn trọng với những sản phẩm có nguồn gốc từ nhựa, hạn chế cho trẻ tiếp xúc với những loại đồ chơi có chứa chất độc hại, phụ huynh khi chọn mua những sản phẩm đồ chơi cho trẻ cần kiểm tra nguồn gốc xuất xứ và thành phần chất liệu được cơ quan chức năng kiểm duyệt, đóng dấu hợp quy, nhãn mác đối với các sản phẩm để tránh nguy cơ ảnh hưởng đến sự phát triển và sức khỏe của trẻ.